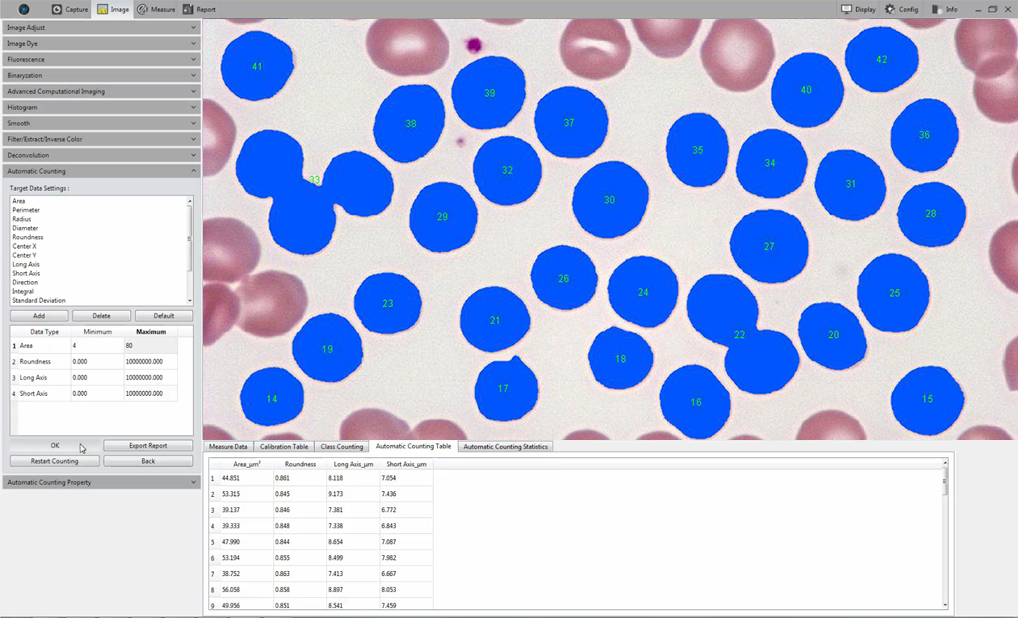

Mosaic V2.3 (CMOS)
Efficient image acquisition - editing - measurement - report output
From the user's point of view, redefining the image acquisition - editing - measurement - report output workflow process, taking into account the best operating procedures, greatly saves the operating time, effectively improving productivity.

Cross-platform solution that supports multiple operating systems such as Windows / Mac / Linux
(1).png)
Mosaic at this stage has been fully supported in the windows & Mac system,
Other systems together with more advanced image processing functions are coming soon!……

.png)







